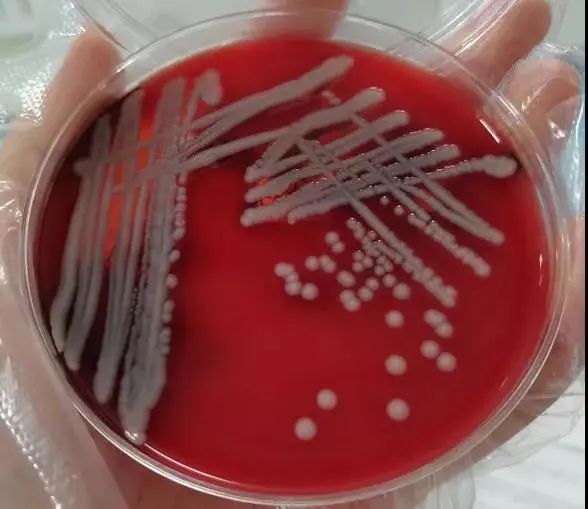
血琼脂平板培养基

【操作技巧】光洁平整不产气泡的血平板怎么制作?小技巧送您!
发布时间:2022-06-08 浏览次数:2546
血琼脂平板培养基,主要用于链球菌及其他苛养菌(对生长环境、营养要求较苛刻的细菌)的分离、培养或用于细菌溶血现象的观察(如金黄色葡萄球菌、单核细胞增生李斯特氏菌等)。
1、成分
其中的蛋白胨和牛肉粉主要提供细菌生长所需要的碳源、氮源、氨基酸及维生素。氯化钠维持培养基中的渗透压,琼脂用做凝固剂。脱纤维羊血一方面提供一些特殊的生长因子,另一方面用于观察溶血反应。
2、制法
根据要求选择取不同的学琼脂平板基础,如营养琼脂、豆粉琼脂或哥伦比亚琼脂(用于营养要求较高的细菌的培养及溶血试验)等,加蒸馏水溶解后,高压灭菌。冷却至50~55℃,加入一定量的羊血,缓慢混匀后倾注平板。注意一定要冷却后再加入羊血,否则红细胞有可能会破碎。
3、制备光洁平整不产气泡的血平板技巧
自制的血平板有时会出现气泡,坑洼凹凸不平的现象,如图所示。

原因分析:
很有可能是倾注培养基时培养基带有气泡,倾注平板,凝固后所致。
解决步骤:
(1)培养基灭菌后置水浴50-55℃保温。
(2)血液一般冷藏。提前取出血液放置在室温下,自然升温至室温。
(3)向培养基中添加血液。移液管吸取血液后加入培养基时,缓慢放液,同时缓慢摇动三角瓶使相互混匀。
(4)倾注培养基后,找平稳地方(越水平越好)冷却。
(5)收皿叠放保存。
错误操作:
(1)培养基灭菌后高温直接加血倾注,皿盖水汽很多,造成后续影响。
(2)血液如果直接从冰箱里拿出来就马上加入培养基,由于温差较大,加入后很容易形成片状凝固。
(3) 放液太快容易形成片状凝固。摇动太剧烈会形成气泡,培养基粘度大气泡形成后很难消除。
(4)如果不是平面,液体保持水平,而皿是斜的,最后造成培养基在某一直径上形成一边高一边低的现象。
(5)不可急着收皿或急脾气急着查看皿凝固了没有。有时候看似凝固了,只是表面,倒过来或移动后以会造成培养基坍塌或坑洼不平。
